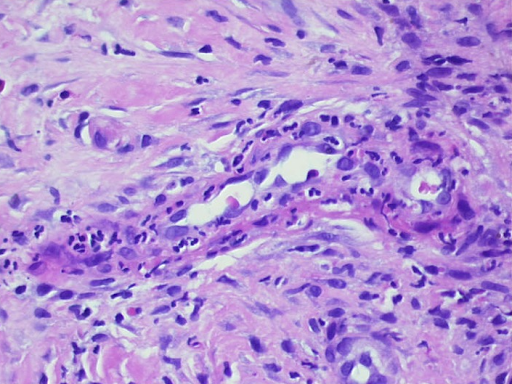
b
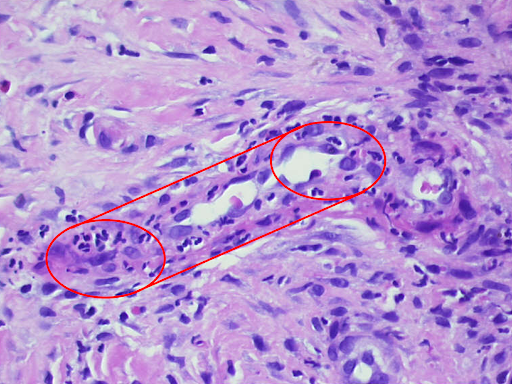
c
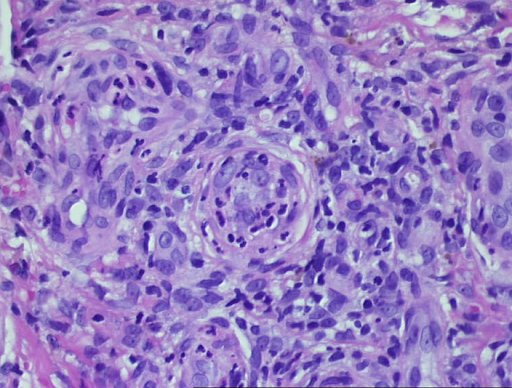
d

Histologie:
Leukozytoklastische Vaskulitis mit ausgeprägter Hämorrhagie.
Therapie und Verlauf:
Die dermatologische "Blickdiagnose" folgt der deutlich erkennbaren Trias aus 1. "palpabler Purpura", 2. exanthematischem Streuphänomen und der 3. "palmoplantarer Beteiligung" sowie dem korrelierenden zeitlichen Zusammenhang von antibiotisch und mit NSAR behandeltem Infekt.
Vaskulitiden sind entzündliche Erkrankungen der Blutgefäßwände. Die uneinheitliche Klassifikation erfolgt traditionell nach Größe der befallenen Gefäße. Aus dermatologischer Sicht ist es sinnvoll, kutane Vaskulitiden mit hauptsächlichem Hautbefall von systemischen Vaskulitiden zu unterscheiden. Die Vasculitis allergica oder synonym Purpura anaphylactoides ist die häufigste der kutanen Vaskulitiden und betrifft vor allem die kleinen und kleinsten Blutgefäße, v.a. die postkapillären Venolen.
Ätiopathologisch lagern sich Immunkomplexe an den Gefäßwänden im Sinne einer Immunkomplextyp-Allergie (Typ III nach Coombs und Gell) ab. Die Entzündung mit Anlocken von massenhaft Leukozyten folgt einer Aktivierung des Komplementsystems. Überwiegend sind IgA-Antikörper beteiligt. Die Granulozyten lagern sich in die Gefäßwand ein und führen durch Bildung von Enzymen und Sauerstoffradikalen zu deren Schädigung. Die Gefäßwandschädigung an den Venolen führt zu lokalen Blutaustritten mit Entstehung der pathognomonischen palpablen Purpura. Im vorliegenden Fall führte die Gerinnungshemmung zu einem besonders starken Blutaustritt aus den Gefäßen. Charakteristisch ist immer Beginn an den orthostatisch belasteten Unterschenkeln.
Abb. 2 zeigt zum Vergleich eine beginnende Vasculitis allergica ohne Gerinnunsghemmung:

a

b

c
Abb. 2: Bei einer 23-jährigen Studentin hatte sich im Zuge eines streptogenen Racheninfektes zunehmend ein purpurisches Exantem an den Unterschenkeln entwickelt (a,b), zunehmend bestünde leichte Schmerzhaftigkeit. Im Dermatoskop stellen sich die nicht wegdrückbaren punktförmigen Hämorrhagien (Purpura) gut dar (c). Der Zusammenhang mit dem bakteriellen Infekt als Träger erscheint wahrscheinlich, wenngleich auch bereits eingenommene NSAR ursächlich sein könnten.
Da die beteiligten Granulozyten beim Durchwandern der Gefäßwände selbst zugrunde gehen, bezeichnet man diese Erkrankung auch als leukozytoklastische Vaskulitis (Abb. 3).

a
b
c
d

e
Abb. 3: Histologischer Befund einer leukozytoklastischen Vaskulitis in der Übersicht, die Epidermis ist partiell zerstört und abgehoben, es besteht ein massives zelluläres Infiltrat der Dermis (a). In den Gefäßen und den Gefäßwänden finden sich segmentkernige Granulozyten. Fibrinoide Nekrose der Gefäßwände und zerfallende Granulozyten, die auch perivaskulär abgelagert sind (b,c). Residuale Obstruktion und Infarzierung kleiner kutaner Blutgefäße (d,e).
Bei Gefäßthrombosierung entwickeln sich teils großflächige Nekrosen. Vor dem Hintergrund einer oralen Antikoagulation, wie im vorliegenden Fall, sind die Blutaustritte prominenter und dauern länger. Dann kann es zur Entstehung der hämorrhagischen Blasen kommen. Entscheidend ist es, das rasch progrediente Krankheitsbild zu erkennen und rechtzeitige therapeutische Maßnahmen zu treffen. Die Histologie beweist lege artis die Diagnose, allerdings ist die Probenentnahme wenig angenehm für die Patienten und der Befundbericht steht zumeist erst viele Tage später zur Verfügung. Daher ist eine Behandlung nach klinischem Befund sinnvoll.
Zunächst gilt es, mögliche Triggerfaktoren zu erkennen und wenn möglich abzuschalten. Bei der akuten Vasculitis allergica können dies zunächst ganz häufig respiratorische (vor allem junge Patienten) oder urogenitale Infekte sein. Häufig sind bakterielle Antigene (z.B. Streptokokkeninfektion) und virale Antigene (z.B. Hepatitis A, Hepatitis B). Anderseits können auch die antibiotische Therapie eines Infektes (v.a. Sulfonylharnstoffpräparate) oder die Behandlung mit NSAR (Salicylate) ursächlich sein. Mögliche Ursachen einer chronischen Vaskulitis sind Fremdeiweiße (z.B. Serumkrankheit) oder Autoantigene (z.B. Kollagenosen, Neoplasien).
Im vorliegenden Fall war entsprechend der Anamnese am ehesten das Cotrimoxazol das auslösende Agens, welches dementsprechend abgesetzt wurde. Im Falle der betroffenen Studentin (Abb. 2) schien eher die streptogene Triggerung wahrscheinlich.
Diese Unterscheidung ist wesentlich, da es bei infektreaktiver Situation ggf. eines Antibiotikums bedarf, im Falle einer Arzneimittelreaktion jedoch eher eines systemischen Steroids. Im Zweifelsfalle kann auch die Kombination beider Behandlungsansätze sinnvoll sein. Lokal sollte in jedem Fall ein stark wirksames Steroid wie Mometason, Betamethason (Klasse III) oder Clobetasol (Klasse IV) in Kombination mit einer Unterschenkelkompression appliziert werden. In ausgeprägten Fällen kann auch ein kurzer Steroidstoß beginnend mit 1mg/kg KG und raschem Ausschleichen sinnvoll sein.
Im vorliegenden Fall wurde der Patient dermatologisch stationär eingewiesen und mit initial Clobetasol und im weiteren Mometason lokal über insgesamt 2 Wochen und über 7 Tage mit zusätzlich Prednisolon p.o. behandelt. Unter der Behandlung kam es zur sofortigen raschen Abheilung unter Hinterlassen von diskret-flachen Narben und postinflammatorischen Hyperpigmentierungen. Im Fall der oben erwähnten Studentin (Abb. 2) genügten die lokale steroidale Therapie und Unterschenkelkompression zur Abheilung ad integrum. Dies zeigt die Bedeutung des raschen Erkennens und der sofortigen Therapieeinleitung.
Bei chronischen Verlaufsformen bestehen gute Erfahrungen mit der Therapie mit systemischem Dapson. Allgemein bei schweren chronischen Vaskulitiden kommen MTX und Azathioprin sowie monoklonale Antikörper wie Rituximab zur Anwendung. Vor allem bei kleinen Kindern sollte bei einer Trias aus Darmkoliken, Gelenkschmerzen und tastbarer Purpura an den Beinen an die Purpura Schönlein-Henoch, einer Sonderform der Vasculitis allergica, gedacht werden. Prognosebestimmend ist hier zumeist eine Immunkomplex-Nephritis. Neben kutanen Vaskulitis-Symptomen bestehen hier auch Bauchschmerz, Gelenk- und Flankenschmerzen und ein deutlich reduzierter Allgemeinzustand. Blutige Diarrhö, Hämaturie und Gelkenködeme durch Extravasate sind für schwerere Fälle typisch. Immer sollten der Urinstatus einschließlich Albumin und die Nierenwerte einschließlich der GRF überprüft werden. Auslöser sind zumeist 1 bis 3 Wochen vorangegangene bakterielle und virale Infekte. Unbehandelt kann es in Extremfällen zu akralen Nekrosen der Gliedmaßen und sogar zu letalen Verläufen kommen.
Fazit: Dermatologischer Notfall Vasculitis allergica
Die Vasculitis allergica ist eine dermatologische Notfallsituation. Es handelt sich um die häufigste Form einer kutanen Vaskulitis. Rechtzeitige Diagnose und Therapie ermöglichen in den allermeisten Fällen ein rasches und residuenarmes Abheilen. Die häufigsten Trigger sind bakterielle und virale Antigene, Antibiotika und Therapie mit NSAR. Die eindeutige Diagnosesicherung erfolgt über den hautbioptischen Nachweis einer leukozytoklastischen Vaskulitis. Die Therapiestrategie beinhaltet das Ausschalten von Triggerfaktoren wenn möglich, eine lokale steroidale Therapie einschließlich Kompressionsbehandlung der unteren Extremitäten und in schweren und chronifizierenden Fällen den Einsatz systemischer Steroide und anderer Immunsuppressiva. Eine im Kindesalter gefürchtete Sonderform der Vasculitis allergica ist die Purpura Schönlein-Henoch.





